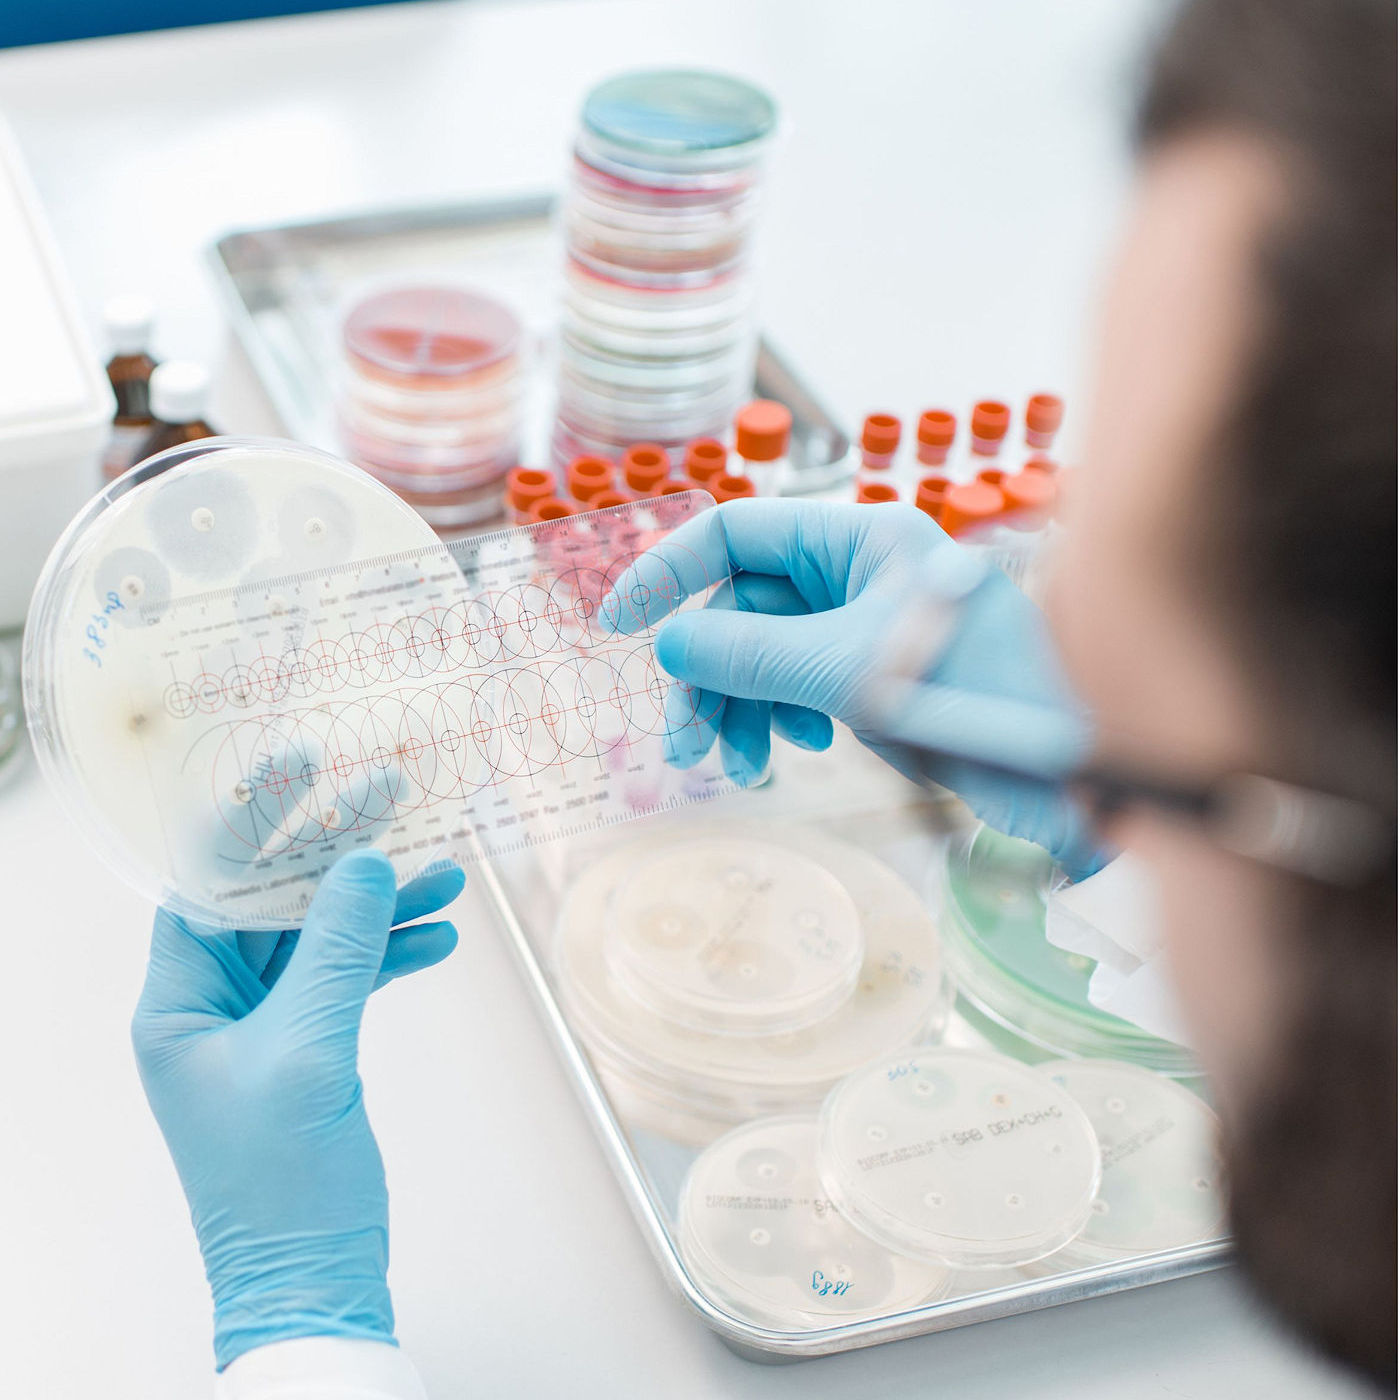

Leadership in Antimicrobial Innovation
Leadership in Antimicrobial Innovation
At Natureza Research, our team brings together decades of experience in infectious disease research, formulation science, and international collaboration. Each member contributes to Natureza’s mission to advance scientifically validated, resistance-aware antimicrobial design and development.
Natureza Patents New Antimicrobial Agents
Natureza Patents New Antimicrobial Agents
Natureza’s findings contribute to new perspectives in antimicrobial development by addressing long-standing challenges associated with development cost and resistance pressure. By focusing on formulation-based antimicrobial strategies rather than traditional systemic drug discovery, this approach supports a more sustainable path for advancing antimicrobial technologies. This would allow a new investment environment to emerge that would encourage the development of new, much-needed antibiotics.
This work is protected by issued and pending U.S. and foreign patents.